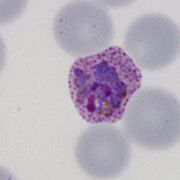
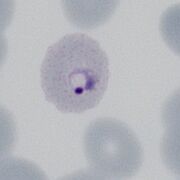
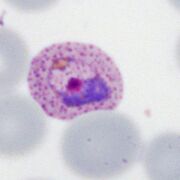
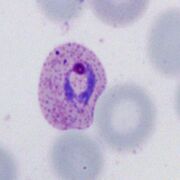

Uploads by Admin
This special page shows all uploaded files.
| Date | Name | Thumbnail | Size | Description | Versions |
|---|---|---|---|---|---|
| 10:57, 4 April 2024 | PVLT2.jpg (file) | |
40 KB | 1 | |
| 10:57, 4 April 2024 | PVLT1.jpg (file) |  |
42 KB | 1 | |
| 14:03, 3 April 2024 | PVET4.jpg (file) |  |
43 KB | 1 | |
| 14:02, 3 April 2024 | PVET3.jpg (file) |  |
30 KB | 1 | |
| 14:02, 3 April 2024 | PVET2.jpg (file) |  |
33 KB | 1 | |
| 14:01, 3 April 2024 | PVET1.jpg (file) | |
48 KB | 1 | |
| 12:06, 3 April 2024 | Schuf4.jpg (file) |  |
54 KB | 1 | |
| 12:05, 3 April 2024 | Schuf3.jpg (file) | |
56 KB | 1 | |
| 12:05, 3 April 2024 | Schuf2.jpg (file) | |
58 KB | 1 | |
| 12:05, 3 April 2024 | Schuf1.jpg (file) |  |
54 KB | 1 | |
| 18:30, 2 April 2024 | PVET main.jpg (file) |  |
37 KB | 1 | |
| 12:41, 30 March 2024 | MB3.jpg (file) |  |
66 KB | 1 | |
| 12:41, 30 March 2024 | MBi2.jpg (file) |  |
30 KB | 1 | |
| 12:41, 30 March 2024 | MB1.jpg (file) |  |
53 KB | 2 | |
| 15:20, 28 March 2024 | Pig5.jpg (file) |  |
51 KB | 1 | |
| 15:19, 28 March 2024 | Pig4.jpg (file) |  |
62 KB | 1 | |
| 15:19, 28 March 2024 | Pig3.jpg (file) |  |
62 KB | 1 | |
| 15:19, 28 March 2024 | Pig2.jpg (file) |  |
65 KB | 1 | |
| 15:13, 28 March 2024 | Pig1.jpg (file) |  |
60 KB | 1 | |
| 13:30, 26 March 2024 | Schizontcartoon4.jpg (file) |  |
86 KB | 1 | |
| 13:29, 26 March 2024 | Schizontreal4.jpg (file) |  |
60 KB | 1 | |
| 13:29, 26 March 2024 | Schizontreal3.jpg (file) |  |
114 KB | 1 | |
| 13:29, 26 March 2024 | Schizontcartoon3.jpg (file) |  |
113 KB | 1 | |
| 13:28, 26 March 2024 | Schizontreal2.jpg (file) |  |
32 KB | 1 | |
| 13:28, 26 March 2024 | Schizontcartoon2.jpg (file) |  |
86 KB | 1 | |
| 13:26, 26 March 2024 | Schizontreal1.jpg (file) |  |
46 KB | 1 | |
| 13:25, 26 March 2024 | Schizontcartoon1.jpg (file) |  |
60 KB | 1 | |
| 22:08, 24 March 2024 | 8SizePVLT.jpg (file) |  |
93 KB | 1 | |
| 22:08, 24 March 2024 | 7SizePVET.jpg (file) |  |
55 KB | 1 | |
| 22:00, 24 March 2024 | 6SizePOLT.jpg (file) |  |
55 KB | 1 | |
| 21:59, 24 March 2024 | 5SizePOET.jpg (file) |  |
69 KB | 1 | |
| 21:25, 24 March 2024 | 4SizePFLT.jpg (file) |  |
47 KB | 1 | |
| 21:25, 24 March 2024 | 3SizePMET.jpg (file) |  |
50 KB | 1 | |
| 19:10, 24 March 2024 | 2SizePMLT.jpg (file) |  |
64 KB | 1 | |
| 19:10, 24 March 2024 | 1SizePMET.jpg (file) |  |
81 KB | 1 | |
| 14:13, 24 March 2024 | James1.jpg (file) |  |
48 KB | 1 | |
| 14:07, 24 March 2024 | Schuffner1.jpg (file) |  |
43 KB | 1 | |
| 14:01, 24 March 2024 | Maurer2.jpg (file) |  |
50 KB | 1 | |
| 14:01, 24 March 2024 | Maurer1.jpg (file) |  |
57 KB | 1 | |
| 12:25, 24 March 2024 | PHincorrect.jpg (file) |  |
83 KB | 1 | |
| 12:24, 24 March 2024 | PHcorrect.jpg (file) |  |
70 KB | 1 | |
| 18:46, 23 March 2024 | PVETc.jpg (file) |  |
67 KB | 1 | |
| 18:42, 21 March 2024 | PFSc2.jpg (file) |  |
45 KB | 1 | |
| 00:41, 21 March 2024 | PFG4.jpg (file) |  |
44 KB | 1 | |
| 00:41, 21 March 2024 | PFG3.jpg (file) |  |
31 KB | 1 | |
| 00:41, 21 March 2024 | PFG2.jpg (file) |  |
40 KB | 1 | |
| 00:40, 21 March 2024 | PFS3p.jpg (file) |  |
43 KB | 1 | |
| 00:40, 21 March 2024 | PFS2p.jpg (file) |  |
56 KB | 1 | |
| 00:40, 21 March 2024 | PFS1p.jpg (file) |  |
27 KB | 1 | |
| 00:20, 21 March 2024 | PFLT5p.jpg (file) |  |
58 KB | 1 |